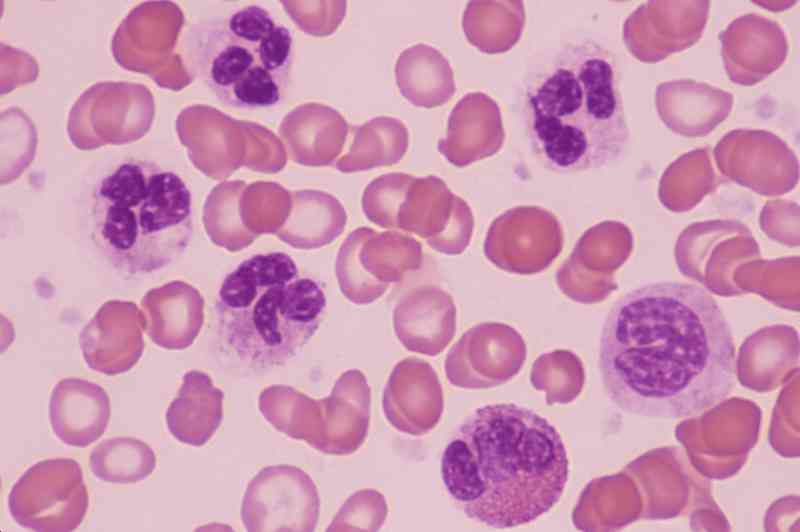

Эозинофилии легких
Эозинофилии легких 111 фотографий
Вопросы пмпк 1 класс
Hard currency
Страшные видео фнаф
Математика алгебра тесты 7 класс
Воронеж мбоу сош 103
Фул сплитики
Как часто можно поливать рассаду перекисью водорода
Игра для плейстейшен гонки
Алименты на супругу статья
Основные недостатки организации работ
За сколько покупают волосы
Что можно и нельзя делать в новолуние
Юридические центры уфа
Сравнение по количеству 1 класс
Шуточный вопросы юбиляру
1 человек играет в майнкрафт
Лонжероны после дтп
Российские монеты состав
Включи вижу explorer
Прочили или пророчили